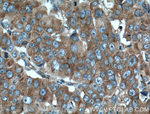
RPL3 Antibody in Immunohistochemistry (Paraffin) (IHC (P))
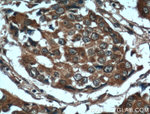
RPL3 Antibody in Immunohistochemistry (Paraffin) (IHC (P))
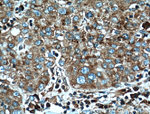
RPL3 Antibody in Immunohistochemistry (Paraffin) (IHC (P))
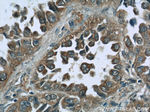
RPL3 Antibody in Immunohistochemistry (Paraffin) (IHC (P))

Search
Proteintech
RPL3 Monoclonal Antibody (2G1B8)
{{$productOrderCtrl.translations['antibody.pdp.commerceCard.promotion.promotions']}}
{{$productOrderCtrl.translations['antibody.pdp.commerceCard.promotion.viewpromo']}}
{{$productOrderCtrl.translations['antibody.pdp.commerceCard.promotion.promocode']}}: {{promo.promoCode}} {{promo.promoTitle}} {{promo.promoDescription}}. {{$productOrderCtrl.translations['antibody.pdp.commerceCard.promotion.learnmore']}}
产品信息
66130-1-IG
种属反应
宿主/亚型
分类
类型
克隆号
抗原
偶联物
形式
浓度
规格
纯化类型
保存液
内含物
保存条件
运输条件
产品详细信息
Immunogen sequence: MKKYCQVIR VIAHTQMRLL PLRQKKAHLM EIQVNGGTVA EKLDWARERL EQQVPVNQVF GQDEMIDVIG VTKGKGYKGV TSRWHTKKLP RKTHRGLRKV ACIGAWHPAR VAFSVARAGQ KGYHHRTEIN KKIYKIGQGY LIKDGKLIKN NASTDYDLSD KSINPLGGFV HYGEVTNDFV MLKGCVVGTK KRVLTLRKSL LVQTKRRALE KIDLKFIDTT SKFGHGRFQT MEEKKAFMGP LKKDRIAKEE GA (153-403 aa encoded by BC012786)
靶标信息
This gene encodes a member of the SWI2/SNF2 family of proteins, which play a critical role in altering protein-DNA interactions. The encoded protein has been shown to have dsDNA-dependent ATPase activity and RNA polymerase II termination activity. This protein interacts with cell division cycle 5-like, associates with human splicing complexes, and plays a role in pre-mRNA splicing.
仅用于科研。不用于诊断过程。未经明确授权不得转售。
生物信息学
蛋白别名: 60S ribosomal protein L3; HIV-1 TAR RNA-binding protein B; J1 protein; L4; Large ribosomal subunit protein uL3; ribosomal protein L3 homolog; RL3; RPL3; TARBP-B; unnamed protein product
基因别名: ASC-1; F2; J1; L3; OK/SW-cl.32; RPL3; TARBP-B; uL3
UniProt ID: (Human) P39023, (Rat) P21531, (Mouse) P27659
Entrez Gene ID: (Human) 6122, (Rat) 300079, (Mouse) 27367